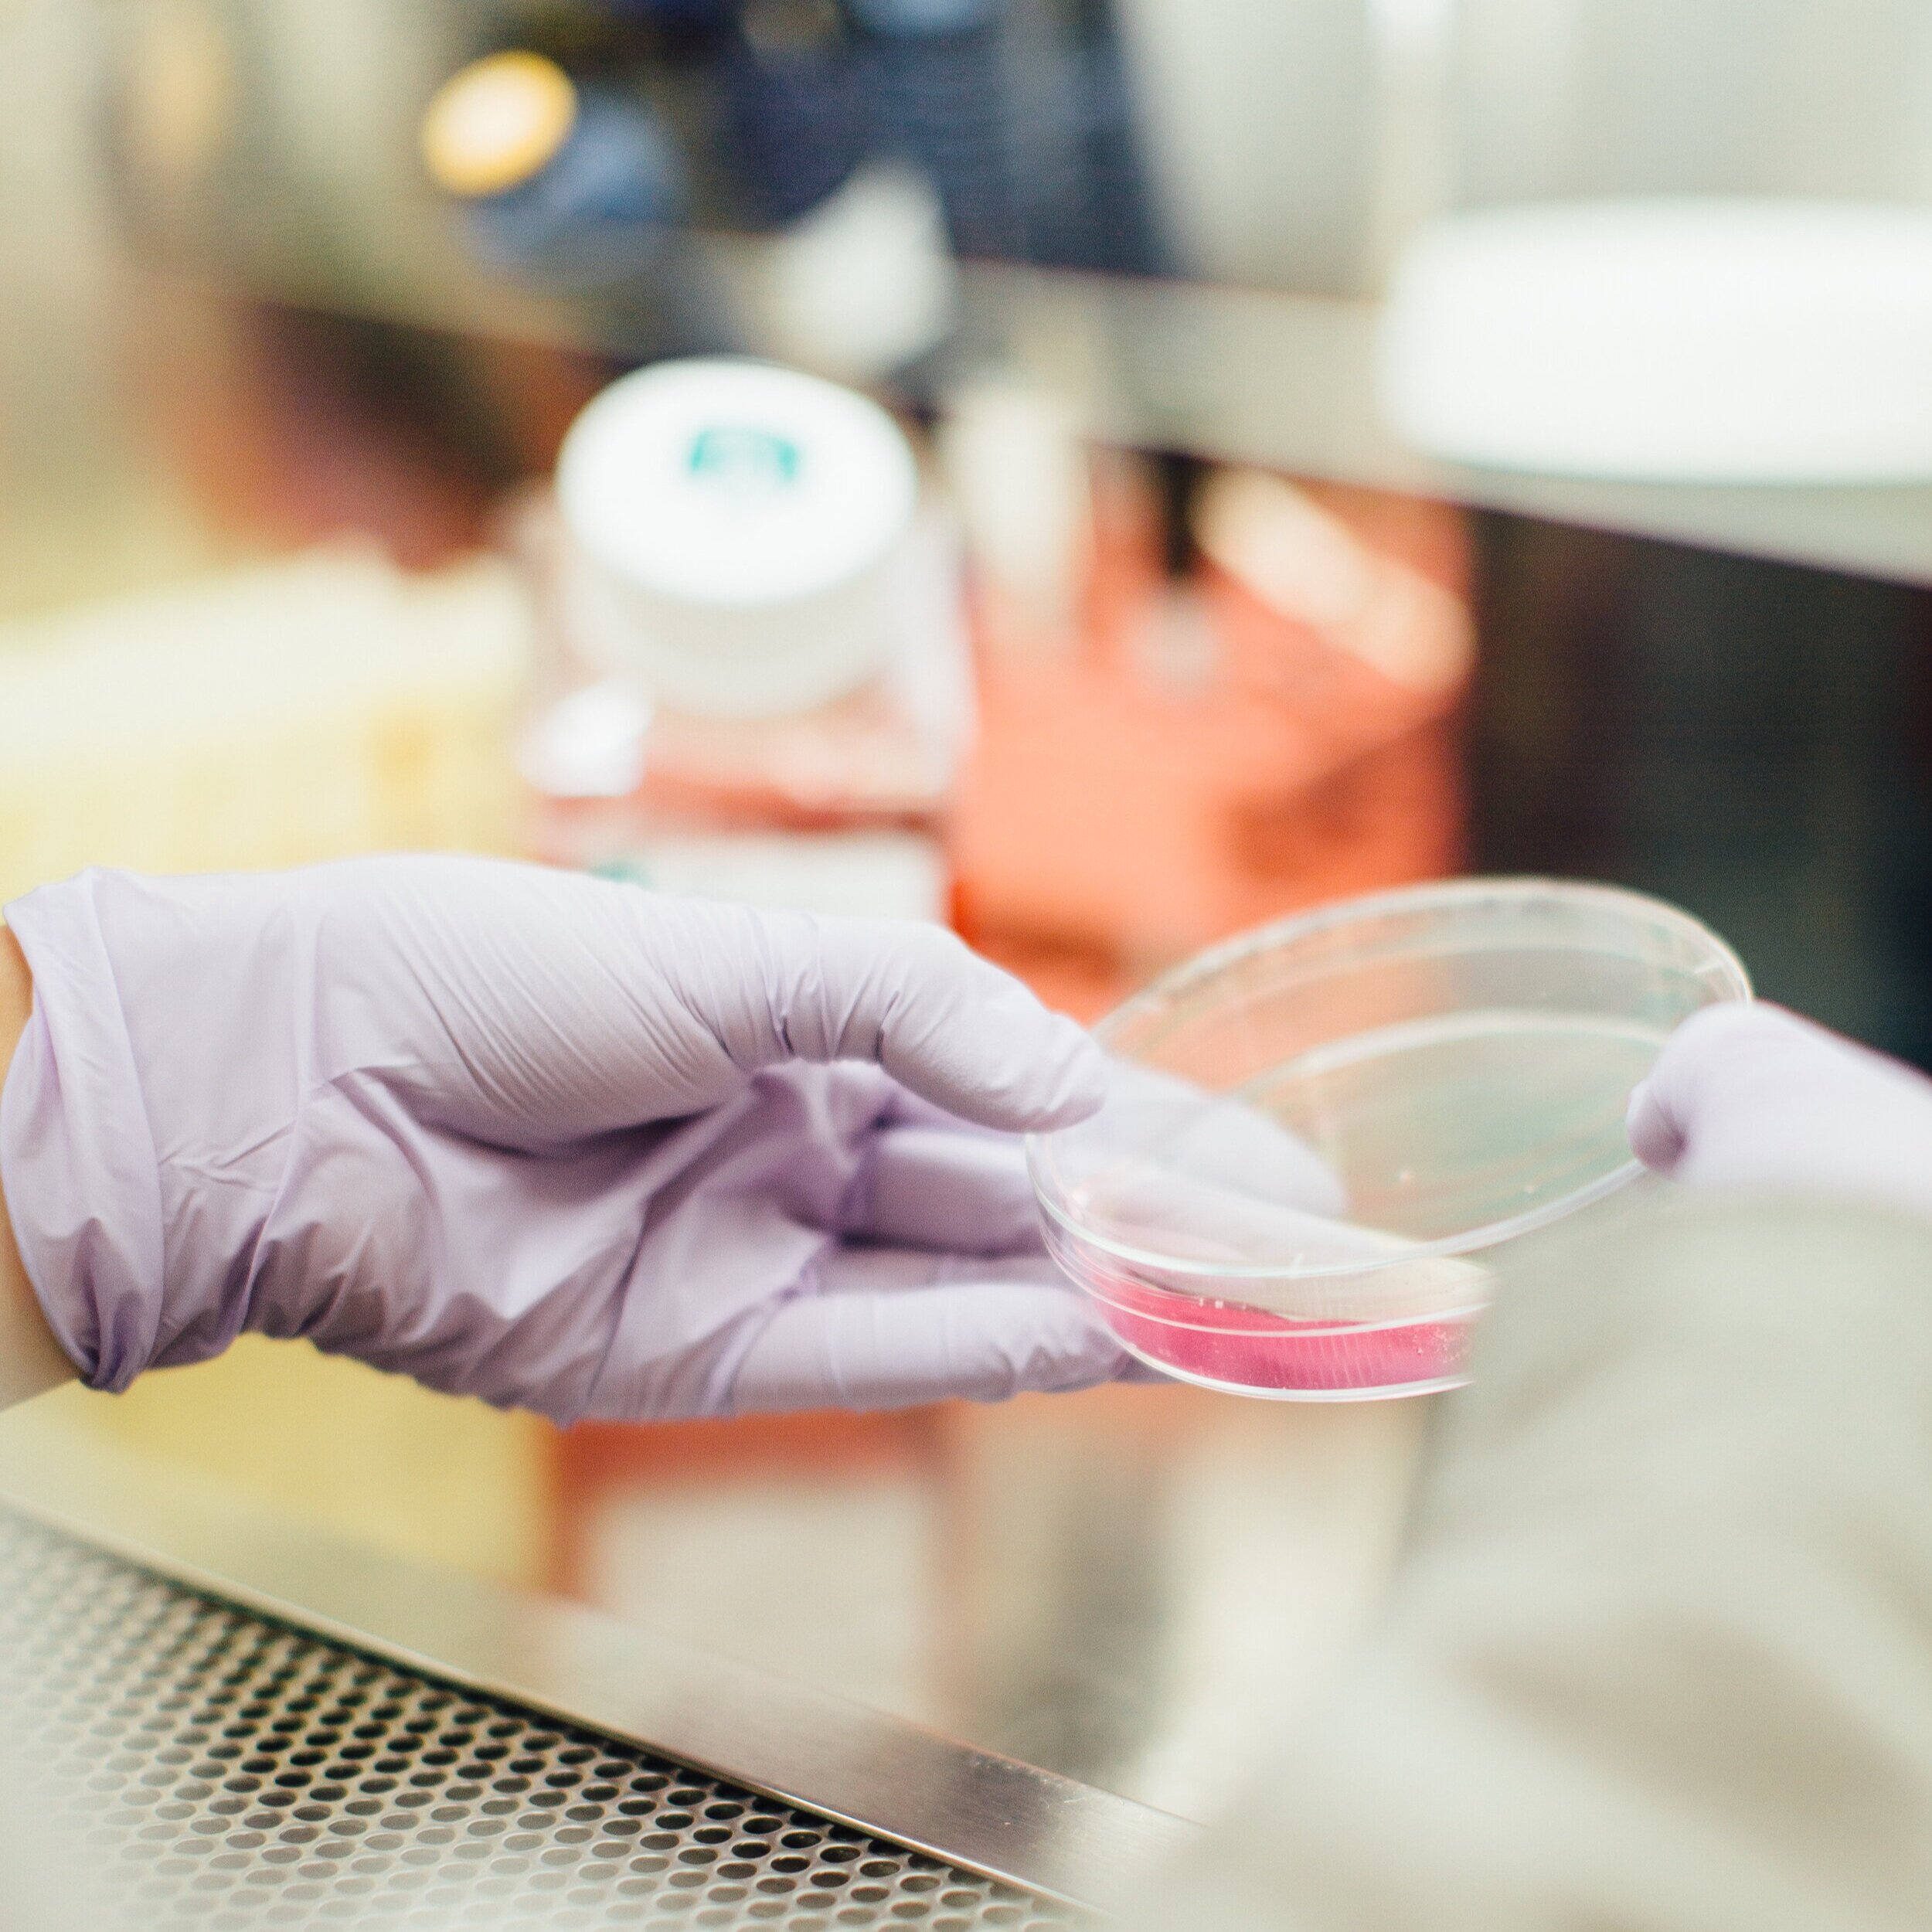

NY Biomedical Technician Rapid Response Team
The Biomedical Technician Rapid Response team is a coalition of volunteer professional scientists that are eager to mobilize and use their laboratory training to help increase community testing for the COVID-19 pandemic and in anticipation of other biomedical emergency situations that threaten public health.
We propose to bring widespread and accessible community testing directly to the people through the deployment of mobile medical units into the community that will collect samples and bring them back to our laboratory for testing.
Our goal is to bring testing to everyone in NYC, regardless of gender, race, age, ethnicity, religion, sexual orientation, income level, neighborhood of residence, employment status or citizenship status.
You can read about our organizing efforts in Nature News.
The Pop-Up Lab
Our lab is located at the SUNY Downstate Incubator within Miramus Inc's laboratory space and is fully staffed, run and operated by volunteer Ph.D scientists and graduate students, completely pro bono.
We plan to collect samples from pre-identified COVID-19 “hot spots” in NYC and bring them back to our lab for testing. Data scientists in our group have used machine learning prediction tools and open source data to put together a geographical map that locates positive COVID-19 “hot spots” by zip code in NYC. This map allows us to make evidence-based decisions about where to bring testing first within the five boroughs of NYC.
We will perform both pooled PCR and serological tests for COVID-19 (i.e. testing for viral load and the presence of protective antibodies).
All in all, this system will help people to stay at home and increase testing access for those who cannot reach hospitals or healthcare centers.
The Strategy: Pooled Testing
The BTRRT has designed a strategy where saliva samples from groups of people who are quarantined together or previously existing in close contact (ex: families or employees working in close proximity) will be pooled into a single qPCR reaction to increase throughput of viral detection.
If a group is detected to be positive, our group will follow up with point-of-care PCR tests to narrow down who is positive for COVID-19. As we look to slowly reintegrate back into society, we plan to retest the same pools of people, as exposure to virus can happen at later time points post testing and during different phases of reintegration.
By pooling samples into a single reaction, this will afford us the ability to retest with minimal time and money spent on reagents and maximize the amount of people reached at a time.
Our Volunteers
Our growing list of over 200 volunteers represents universities and medical campuses such as: Mount Sinai Hospital, Columbia University, Weill-Cornell, NYU, Rockefeller University, University of Buffalo, Cornell University, Albany Medical College, SUNY at Buffalo, CUNY Queens and includes education levels ranging from undergraduates to PhD and MD/PhD level scientists.
We have matched volunteers with opportunities such as: 1) testing for COVID-19 presence and viral load, 2) screening serum from recovered COVID patients for protective antibodies and 3) supporting hospital staff with COVID clinical tasks.
Currently, we have placed ~20 volunteers throughout NYC while we work towards opening our pop-up lab.
Volunteer Testimonials
I help process blood samples for COVID-19 antibody tests at Mount Sinai Beth Israel in order to screen high risk medical employees, find plasma donors, and test the impact of convalescent plasma infusions on patient antibody levels.
-Zachary Pennington, Ph.D.
I am helping to conduct research and run COVID ELISA antibody tests in the Center for Clinical Labs at Mount Sinai in order to identify potential donors of convalescent plasma.
-Kirstie Cummings, Ph.D.
Donate
We are a fully volunteer-based workforce. We are looking for funding, supplies, and government support so we can enact our vision of bringing mass surveillance testing to NYC.
contribute
We have started a gofundme to gather funds that will help to offset reagent and equipment cost to perform COVID-19 testing in our laboratory. For Paypal donations, click here.
Donate supplies
We are gratefully accepting donations of PPE, lab consumables, reagents, and testing equipment. Examples of lab equipment we need can be found here.
volunteer
We are looking for scientific professionals to help with testing, experiments, mobile sampling, app development, and administrative tasks.